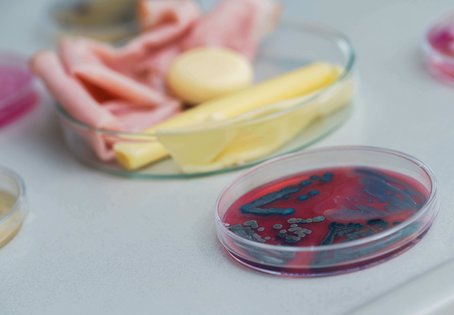

- Startseite /
- Universität /
- Infoservice /
- Presseinformationen /
- Der Haushalt als blinder Fleck der Lebensmittelsicherheit
Forschung
Der Haushalt als blinder Fleck der Lebensmittelsicherheit
Haushaltskühlschränke als unterschätzte mikrobielle Ökosysteme

Haushaltskühlschränke gelten als eine der wichtigsten Barrieren gegen lebensmittelbedingte Infektionen. Sie verlangsamen mikrobielles Wachstum, verlängern Haltbarkeiten und sind ein zentraler Bestandteil der Kühlkette. Eine neue Studie der Vetmeduni zeigt nun jedoch, dass Kühlschränke weit mehr sind als inerte Aufbewahrungsorte: Sie stellen komplexe, dynamische mikrobielle Lebensräume dar – mit direkter Relevanz für Lebensmittelsicherheit, Hygiene und Antibiotikaresistenz.
Das Team um Evelyne Selberherr vom Zentrum für Lebensmittelwissenschaften der Vetmeduni untersuchte erstmals mithilfe hochaufgelöster Shotgun-Metagenomik die mikrobiellen Gemeinschaften auf Kühlschrankoberflächen in privaten Haushalten. Dabei wurden nicht nur Bakterien und Pilze bis auf Artebene identifiziert, sondern auch mikrobielle Belastung quantifiziert und Antibiotika-Resistenzgene systematisch erfasst.
Hygiene schlägt Temperaturkontrolle
Internationale Organisationen wie die WHO, EFSA und FDA empfehlen, Haushaltskühlschränke bei Temperaturen unter 4-5 °C zu betreiben, um das Wachstum pathogener Mikroorganismen zu begrenzen. Während Temperaturprofile in Haushalten bereits mehrfach untersucht wurden, fehlte bislang eine integrative Betrachtung der gesamten mikrobiellen Gemeinschaft – inklusive ihrer funktionellen Eigenschaften. Die neue Studie schließt diese Lücke. In 45 Haushaltskühlschränken wurden Ablageflächen systematisch beprobt, mit umfangreichen Metadaten zu Temperatur, Nutzungsgewohnheiten und Reinigungspraktiken. Das Ergebnis zeichnet ein differenziertes Bild: Kühlschränke sind keineswegs mikrobiologisch inert, sondern beherbergen hochdiverse Gemeinschaften mit mehreren tausend Spezies.
„Die Temperaturmessungen zeigen ein bekanntes, aber weiterhin relevantes Problem: Nur 38 % der untersuchten Kühlschränke lagen unter der empfohlenen Grenze von 5 °C, während 24 % Temperaturen über 7 °C aufwiesen – ein Bereich, der in der Lebensmittelindustrie und -forschung als ungünstiges Worst-Case-Szenario gilt“, erklärt Evelyne Selberherr. Bemerkenswert ist jedoch, dass die Temperatur allein keinen signifikanten Einfluss auf die mikrobielle Diversität zeigte. Kühlschränke mit niedrigen Temperaturen waren nicht automatisch mikrobiologisch „sauberer“. Als entscheidender Faktor erwies sich die Reinigungsfrequenz – genauer gesagt: die Zeit seit der letzten Reinigung.
Mikrobielle Risiken durch mangelnde Kühlschrankhygiene
Kühlschränke, die über längere Zeiträume nicht gereinigt wurden, wiesen deutlich höhere mikrobielle Belastungen (bacterial cell equivalents), geringere Artenvielfalt, und eine Dominanz weniger, besonders anpassungsfähiger Mikroorganismen auf. Diese Struktur ist typisch für reife, stabile mikrobielle Gemeinschaften, wie sie aus Biofilmen bekannt sind. Solche Gemeinschaften sind widerstandsfähiger gegenüber Störungen und können als Reservoir für unerwünschte Mikroorganismen dienen.
Die Ergebnisse legen nahe, dass Hygienepraktiken langfristig stärker wirken als kurzfristige Temperaturunterschiede – ein Aspekt, der in Verbraucherempfehlungen bislang kaum berücksichtigt wird. Die Zusammensetzung der Kühlschrankmikrobiome spiegelt den Alltag wider: Dominant waren psychrotolerante und lebensmittelassoziierte Bakterien wie Acinetobacter, Pseudomonas, Psychrobacter und Brochothrix, ergänzt durch Mikroorganismen aus fermentierten Lebensmitteln sowie typische Vertreter der menschlichen Hautflora. Die hohe taxonomische Auflösung der Metagenomik zeigte dabei, dass selbst innerhalb dominanter Gattungen eine große Artenvielfalt existiert – ein Hinweis auf ständige Neueinträge durch Lebensmittel, Hände und Oberflächenkontakt. „In 60 % der untersuchten Kühlschränke wurden potenziell krankheitserregende Bakterien nachgewiesen. Am häufigsten trat Bacillus cereus auf, gefolgt von Staphylococcus aureus“, so Studien-Erstautor Moritz Hartmann. Klassische Kühlketten-Pathogene wie Listeria monocytogenes wurden zwar nur vereinzelt detektiert, ihre Präsenz unterstreicht jedoch, dass der häusliche Bereich kein risikofreier Endpunkt der Lebensmittelkette ist.
Ein Kühlschrank als Reservoir für Resistenzen
Die Ergebnisse sprechen dafür, dass Kreuzkontaminationen, etwa durch direktes Ablegen unverpackter Lebensmittel oder durch Hände, eine zentrale Rolle spielen. Ein besonders gesellschaftlich relevanter Befund betrifft die Resistom-Analyse: In zahlreichen Kühlschränken wurden Antibiotika-Resistenzgene identifiziert, insbesondere gegen Beta-Laktame, Tetrazykline und Aminoglykoside. Auffällig war eine klare Korrelation zwischen Alter des Kühlschranks und Resistenzgen-Belastung. Ältere Geräte wiesen signifikant höhere Resistom-Level auf – vermutlich durch langfristige Anreicherung stabiler Biofilme.
Damit zeigt die Studie, dass Antibiotikaresistenzen nicht auf klinische Umgebungen beschränkt sind, sondern auch im privaten Haushalt persistieren können. Dieser Befund stärkt den One-Health-Ansatz und erweitert ihn um eine bislang wenig beachtete Dimension. Die Studie macht deutlich: Der Kühlschrank sollte nicht als passiver Lagerort betrachtet werden, sondern als aktive Schnittstelle zwischen Mensch, Lebensmitteln und Mikroorganismen. „Während Temperatur-Empfehlungen weit verbreitet sind, fehlen bislang konkrete, evidenzbasierte Leitlinien zur Kühlschrankhygiene. Unsere Ergebnisse legen nahe, dass einfache Maßnahmen – wie eine regelmäßige Reinigung einen erheblichen Einfluss auf die mikrobiologische Sicherheit haben. Diese Erkenntnisse sind nicht nur für Privathaushalte relevant, sondern auch für sensible Versorgungsbereiche wie Krankenhausküchen, Pflegeeinrichtungen oder Gemeinschaftsverpflegung. Gerade dort, wo besonders vulnerable Personengruppen versorgt werden, sollte die mikrobiologische Bedeutung von Kühlgeräten stärker in Präventionsstrategien integriert werden“, resümiert Evelyne Selberherr.
Fazit: Kälte allein garantiert keine Sicherheit. Erst das Zusammenspiel aus Temperaturkontrolle und Hygiene entscheidet darüber, ob der Kühlschrank Schutz bietet – oder selbst zum mikrobiellen Hotspot wird. Die Studie liefert eine wissenschaftliche Grundlage, um Haushaltskühlschränke neu zu denken: nicht als passive Technologie, sondern als mikrobielles Ökosystem mit direkter Relevanz für öffentliche Gesundheit und Lebensmittelqualität.
Hinweis: Dieses Projekt ist im Rahmen von Sparkling Science/Projekt Micro-Tramper entstanden. Fördergeber ist der OeAD. Informationen zum Micro-Tramper-Projekt finden Sie hier.
Der Artikel "Cold storage, hot spots: Household refrigerators as under-recognized hubs of microbial diversity" von Moritz Hartmann, Monika Dzieciol, Cameron R. Strachan, Narciso M. Quijada und Evelyne Selberherr ist in LWT - Food Science and Technology erschienen.
Wissenschaftlicher Artikel
Rückfragekontakt:
Assoz.Prof. Evelyne Selberherr PhD.
Zentrum für Lebensmittelwissenschaften
Veterinärmedizinische Universität Wien (Vetmeduni)
Evelyne.Selberherr@vetmeduni.ac.at